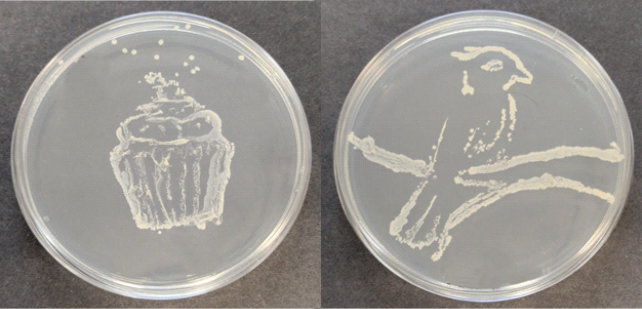
A cupcake and a kookaburra created in agar jelly by shaping bacterial growth

CSES@ARU Science and Engineering Saturday Club 2025
A few words from David, who runs our Saturday Club...
Hello, I am Professor David Humber from Anglia Ruskin University and Vice President of CSES, who runs this club at ARU, Chelmsford.
This year, we explored over a dozen different hands-on topics from infection and microbiology, through CAD design and 3D printing, and even pond dipping, chocolate welding and horology! We also took visits to Essex Wildlife, the Power Museum and our Masterclass at UCL East.
Each year our students seem to get better and the quality of work they submitted for our Agar Art Competition and the posters they produced for the cutting-edge science poster challenge were really impressive.
Finally, thanks to ARU for supporting our club and to the tutors and student ambassadors who helped run the sessions. Also, a big thank-you to our enthusiastic students and their parents and carers who supported and encouraged them.

Keep an eye out for the 2026 Saturday Club, which will open in the new academic year.